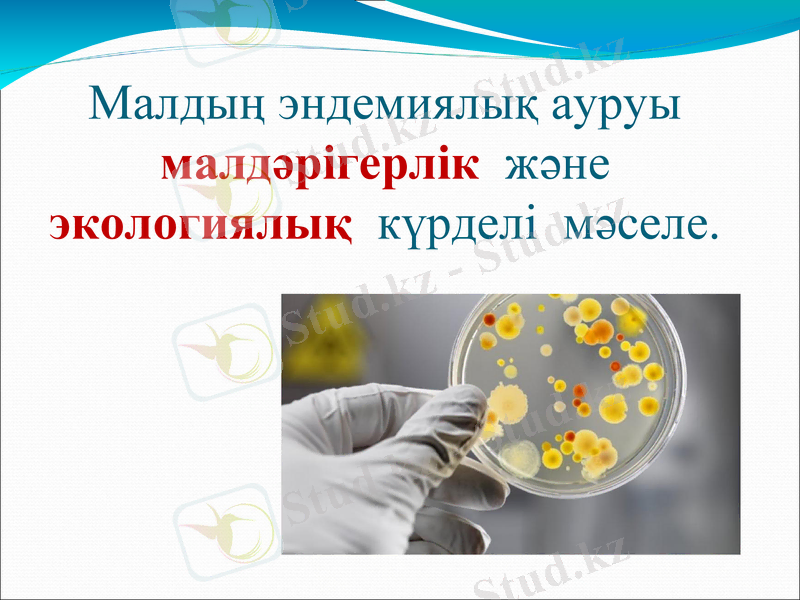
Slide 5

Малдардың эндемиялық энзоотиялары: микроэлементтік дисбаланс пен биогеоценотикалық диагностика



Орындаған:Қалымова З. А.
Тексерген:Жайлаубаева А. Р.

Эндемиялық (гректің endemos- жергілікті) аурулар геохимиялық энзоотияға жатады. Олар аумақтық биогеохимиялық ерекшелігіне сәйкес мал басын шалдықтырады.

Эндемиялық аурудың белгілері:
Қондылығының, өнімділігінің төмендеуі;
Тері мен тері түгінің, кілегей қабықтың өзгеруі және т. б.

Эндемикалық ауру
Өсімдікте
(эпифитогия)
Малда
(эпизоотия)
Адамда
(эпидемия)
Малдың эндемиялық ауруы малдәрігерлік және экологиялық күрделі мәселе.

Бүгінгі күнде мал организмінде 80-нен астам минералды элементтер анықталған, олар әр түрлі мөлшерде жиналған, оның ішінде денсаулыққа күшті ықпал ететін биогенді микроэлементтерге темір, мыс, мырыш, йод, марганец, кобальт, молибден, селен, никель, қалайы, фтор, ванадий, сифонций,
хром т. б. жатады.

Малдардың эндемиялық ауруы

Егер азот құрамдас химиялық заттың алмасу айналымы бұзылса ақзаттың алмасуы бұзылып, малдың өсіп-өнуі, өсімталдығы, өнімділігі төмендейді.

Фосфордың алмасып. айналуының бұзылуынан, яғни ол жетіспесе, малдың афосфорода остеодистрофия, остеомаляция, остеопороз, остеолиз, ал фосфор шектен тыс көп болса, онда ацидозды (гиперфосфорлы) остеодистрофил байқалады.

Малдардың эндемиялық ауруларына қарсы дәрі-дәрмектер


Дәрі -дәрмекті қолданатын препараттар

Биогеохимиялық энзоотияны, оның ішінде эндемиялық ауруларды, биогеоценотикалық тәсілмен анықтау үшін :
Малға, оның ағзалары, ұлпалары, торшалары, субторшалық құрамдарына;
Популяцияға(үйір, отар, табын) ;
Биогеоценозға (экологиялық, жүйе, ланшафт) баға беруіміз керек.

Пайдаланған әдебиеттер тізімі:
М. А. Молдағұлов, А. Н. Ермаханов, Ө. К. Есқожаев, А. З. Дюсембаевна, А. Т. Қамбарбеков, А. И. Көлдеев, Б. Д. Айтжанов, Ж. І. Қазиев, С. Т. Сиябеков. «Жануарлар ауруларының клиникалық диагностикасы» Алматы, 2014ж 241-244 беттер
- Іс жүргізу
- Автоматтандыру, Техника
- Алғашқы әскери дайындық
- Астрономия
- Ауыл шаруашылығы
- Банк ісі
- Бизнесті бағалау
- Биология
- Бухгалтерлік іс
- Валеология
- Ветеринария
- География
- Геология, Геофизика, Геодезия
- Дін
- Ет, сүт, шарап өнімдері
- Жалпы тарих
- Жер кадастрі, Жылжымайтын мүлік
- Журналистика
- Информатика
- Кеден ісі
- Маркетинг
- Математика, Геометрия
- Медицина
- Мемлекеттік басқару
- Менеджмент
- Мұнай, Газ
- Мұрағат ісі
- Мәдениеттану
- ОБЖ (Основы безопасности жизнедеятельности)
- Педагогика
- Полиграфия
- Психология
- Салық
- Саясаттану
- Сақтандыру
- Сертификаттау, стандарттау
- Социология, Демография
- Спорт
- Статистика
- Тілтану, Филология
- Тарихи тұлғалар
- Тау-кен ісі
- Транспорт
- Туризм
- Физика
- Философия
- Халықаралық қатынастар
- Химия
- Экология, Қоршаған ортаны қорғау
- Экономика
- Экономикалық география
- Электротехника
- Қазақстан тарихы
- Қаржы
- Құрылыс
- Құқық, Криминалистика
- Әдебиет
- Өнер, музыка
- Өнеркәсіп, Өндіріс
Қазақ тілінде жазылған рефераттар, курстық жұмыстар, дипломдық жұмыстар бойынша біздің қор #1 болып табылады.



Ақпарат
Қосымша
Email: info@stud.kz